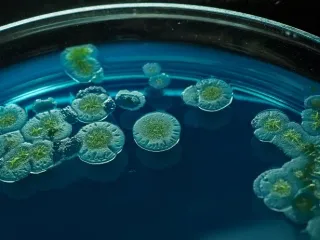

Disponible
Accès 1 utilisateur
Accès individuel réservé à un utilisateur
3 000,00 € HT
Idéal pour les indépendants, consultants, analystes ou responsables R&D souhaitant exploiter la donnée pour un usage personnel
L'étude inclut
- + 400 pages d'étude
- Présentation des 5 stratégies d’entrées sur un territoire scientifique
- Présentation de la grille d’évaluation
- Mapping de + de 20 grands territoires
- Mapping des sous-territoires scientifiques du territoire scientifique analysé
- Analyse complète du territoire scientifique (incluant données scientifiques et marché)
- Analyse des différents players par catégorie (science, marketing, communication)
- Conclusion avec opportunités offertes par le territoire scientifique analysé